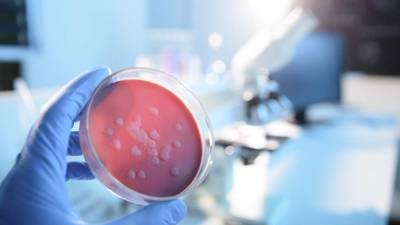

Guía Médica
Estados Unidos
Los trastornos de alimentación pueden empezar antes de la pubertad y podrían estar vinculados con otros problemas de salud mental, según un estudio reciente.
Los investigadores canadienses evaluaron a 215 niños de 8 a 12 años de edad con problemas alimentarios. Más del 15% de los niños se provocaban vómitos de forma ocasional y aproximadamente el 13% tenían conductas parecidas a la bulimia. El 52% de los niños habían sido hospitalizados al menos una vez debido a su problema de alimentación, y el 48 por ciento habían recibido un tratamiento ambulatorio, afirmaron los investigadores.
La bulimia es un trastorno de la alimentación caracterizado por comer y realizar purgas, normalmente mediante el vómito o con laxantes.
'Muchos investigadores creen que la bulimia no aparece hasta la adolescencia, pero nuestros (hallazgos) indican que el problema puede presentarse mucho antes. Es posible que en la actualidad se diagnostique demasiado poco debido a la falta de concienciación y de investigación', señaló la líder del estudio, Dominique Meilleur, psicóloga clínica y profesora en la Universidad de Montreal, en un comunicado de prensa de la universidad.
Había problemas psiquiátricos en el 36 por ciento de las familias de los niños, y muchos de los niños tenían problemas de salud mental, como trastornos de ansiedad, del estado de ánimo y de la atención, según el estudio.
Casi el 23% de los niños dijeron que habían sufrido burlas o insultos por su apariencia, según el estudio. Los resultados se presentaron el 7 de octubre en una reunión de la Asociación de Trastornos de la Alimentación de Canadá (Eating Disorders Association of Canada), en Vancouver.
'Para algunos niños, el acoso puede iniciar o reforzar las preocupaciones por la imagen corporal y posiblemente
llevar a un cambio en la conducta alimentaria', dijo Meilleur.
El 95% de los niños del estudio tenían conductas alimentarias restrictivas, el 69% estaban preocupados por ganar peso y casi el 47% se describieron a sí mismos como 'gordos'.
'Estas conductas reflejan las manifestaciones clínicas que observamos en los adolescentes y respaldan los hallazgos de que la imagen corporal es objeto de preocupación para algunos niños ya en la escuela primaria', señaló Meilleur.
Los investigadores también hallaron que los trastornos de alimentación no son un 'problema de chicas'.
Los hallazgos plantean preguntas sobre el modo en que los trastornos de la alimentación se desarrollan y se diagnostican, concluyó Meilleur.
Los datos y conclusiones presentados en reuniones por lo general se consideran como preliminares hasta que se publiquen en una revista médica revisada por profesionales.
Los trastornos de alimentación pueden empezar antes de la pubertad y podrían estar vinculados con otros problemas de salud mental, según un estudio reciente.
Los investigadores canadienses evaluaron a 215 niños de 8 a 12 años de edad con problemas alimentarios. Más del 15% de los niños se provocaban vómitos de forma ocasional y aproximadamente el 13% tenían conductas parecidas a la bulimia. El 52% de los niños habían sido hospitalizados al menos una vez debido a su problema de alimentación, y el 48 por ciento habían recibido un tratamiento ambulatorio, afirmaron los investigadores.
La bulimia es un trastorno de la alimentación caracterizado por comer y realizar purgas, normalmente mediante el vómito o con laxantes.
'Muchos investigadores creen que la bulimia no aparece hasta la adolescencia, pero nuestros (hallazgos) indican que el problema puede presentarse mucho antes. Es posible que en la actualidad se diagnostique demasiado poco debido a la falta de concienciación y de investigación', señaló la líder del estudio, Dominique Meilleur, psicóloga clínica y profesora en la Universidad de Montreal, en un comunicado de prensa de la universidad.
Había problemas psiquiátricos en el 36 por ciento de las familias de los niños, y muchos de los niños tenían problemas de salud mental, como trastornos de ansiedad, del estado de ánimo y de la atención, según el estudio.
Casi el 23% de los niños dijeron que habían sufrido burlas o insultos por su apariencia, según el estudio. Los resultados se presentaron el 7 de octubre en una reunión de la Asociación de Trastornos de la Alimentación de Canadá (Eating Disorders Association of Canada), en Vancouver.
'Para algunos niños, el acoso puede iniciar o reforzar las preocupaciones por la imagen corporal y posiblemente
llevar a un cambio en la conducta alimentaria', dijo Meilleur.
El 95% de los niños del estudio tenían conductas alimentarias restrictivas, el 69% estaban preocupados por ganar peso y casi el 47% se describieron a sí mismos como 'gordos'.
'Estas conductas reflejan las manifestaciones clínicas que observamos en los adolescentes y respaldan los hallazgos de que la imagen corporal es objeto de preocupación para algunos niños ya en la escuela primaria', señaló Meilleur.
Los investigadores también hallaron que los trastornos de alimentación no son un 'problema de chicas'.
Los hallazgos plantean preguntas sobre el modo en que los trastornos de la alimentación se desarrollan y se diagnostican, concluyó Meilleur.
Los datos y conclusiones presentados en reuniones por lo general se consideran como preliminares hasta que se publiquen en una revista médica revisada por profesionales.